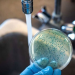
Cholera Outbreak Claims Five Lives in Kenya

Nigeria’s U20 national team, the Flying Eagles, have returned to Abuja as they intensify preparations for the upcoming 24th Africa U20 Cup of Nations set to take place later this month in Egypt.
The seven-time African champions wrapped up a three-week training camp in Katsina, where they were initially based to acclimatize to weather conditions similar to those in Cote d’Ivoire—the original host of the tournament. However, with Cote d’Ivoire pulling out at the last minute, Egypt, which hosted the previous edition in 2023, has stepped in once again as the emergency host.
With the location change, the team has now shifted base to the FIFA Goal Project facility in Abuja, where they will hold their final training sessions before jetting out to Egypt within the next week.

Head Coach Aliyu Zubairu, who guided the team to WAFU B U20 Championship glory in Togo last October, has invited a 35-man provisional squad to the Abuja camp. The squad features a mix of local and overseas-based talents, including three goalkeepers, eight defenders, 10 midfielders, and 14 forwards.
The Flying Eagles will be aiming to finish among the top four at the tournament to secure a ticket to the 2024 FIFA U20 World Cup, scheduled to be held in Chile from September 27 to October 18.
Full Squad List for Abuja Camp:
Goalkeepers:
- Ifeanyi Ebenezer Harcourt (Sporting Lagos)
- Rufai Abubakar (Mavlon FC)
- Soliu Ajia (FK Novi Pazar, Serbia)
Defenders:
- Adewale Quadri (Nath Boys Academy)
- Adamu Maigari (El-Kanemi Warriors)
- Odinaka Okoro Emmanuel (Sporting Lagos)
- Kenneth Igboke (Enugu Rangers)
- Daniel Bameyi (Bayelsa United)
- Haruna Aliyu (Wikki Tourists)
- Chukwu Emmanuel (TSG 1899 Hoffenheim, Germany)
- Chigozie Michael Ihejiofor (Katsina United)
Midfielders:
- Caleb Ochedikwu (NK Ujanik, Croatia)
- Michael Tunde (Simon Ben FC)
- Sabiu Mohammed (Niger Tornadoes)
- Akinniran Oluwashile (Water FC)
- Ibrahim Alani (Real Valladolid, Spain)
- Ayuma Isaac Israel (NK Istra, Croatia)
- Cletus Simon (Mavlon FC)
- Sulaiman Alabi Jojo (El-Kanemi Warriors)
- Auwal Ibrahim (Akwa United)
- Shafiu Adamu Duguri (Wikki Tourists)
Forwards:
- Umar Abubakar (KAA Gent, Belgium)
- Anthony Ezekiel (Inspire FC)
- Otu Joseph (Mavlon FC)
- Nasiru Salihu (El-Kanemi Warriors)
- Divine Oliseh (Forster Academy)
- Adeleke Abdulmuiz (Adoration FC)
- Clinton Jephta (Enyimba FC)
- Bidemi Amole (Real Sapphire FC)
- Tahir Maigana (Wireless FC)
- Rickson Mendos (Niger Tornadoes)
- Mustapha Umar (Kano Pillars)
- Kingsley Matthew (Kings FC)
- Armiyau Yusha’u (Katsina United)
- Benjamin Precious (TSG 1899 Hoffenheim, Germany)
With the tournament just around the corner, the focus in camp is sharp and expectations high. Can the Flying Eagles soar to their eighth continental title and punch their ticket to Chile? All eyes will be on the boys in green and white.